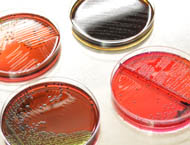

|
||||||
 |
||||||
|
|
|||||
|
Análisis de Aguas Alimentos de Consumo Humano y Animal Salud Laboral Suelos y Residuos Sólidos Inocuidad Agroalimentaria. Mediciones Ambientales
Si necesita hacer una consulta mas específica para |
||||||
| servicios@analiticadelnoroeste.com | ||||||
Teléfonos: Hermosillo, Sonora, México: (662) 216.52.27, 216.00.39 y 218.23.21 Nogales, Sonora, México: Tel. (631) 320.72.89 |
||||||